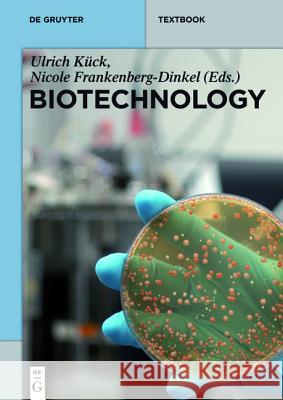
Biotechnology  9783110341102 De Gruyter

» książki » Technology & Engineering - Food Science - General
 |
Food Safety and Quality Systems in Developing Countries: Volume One: Export Challenges and Implementation Strategies
ISBN: 9780128012277 / Angielski / Twarda / 186 str. Termin realizacji zamówienia: ok. 5-8 dni roboczych. Food Safety and Quality Systems in Developing Countries, Volume One: Export Challenges and Implementation Strategies considers both the theoretical and practical aspects of food safety and quality systems implementation by major world markets and new and emerging markets in developing countries. This reference examines issues facing exporters and importers of traditional foods the characteristics of the food and its distribution channels, and market access from a historical and current context to present best practices. This must-have reference offers real-life,... Food Safety and Quality Systems in Developing Countries, Volume One: Export Challenges and Implementation Strategies considers... |
cena:
337,89 |
 |
Edible Seaweeds of the World
ISBN: 9781498730471 / Angielski / Twarda / 463 str. Termin realizacji zamówienia: ok. 5-8 dni roboczych. Seaweed is used in many countries for very different purposes - directly as food, especially in sushi, as a source of phycocolloids, extraction of compounds with antiviral, antibacterial or antitumor activity and as biofertilizers. About four million tons of seaweed are harvested annually worldwide. Of the various species known, less than 20 account for 90% of the biomass exploited commercially. This book details 147 species of edible seaweed, including scientific name and respective common names, geographic location, nutritional composition, uses and is extensively illustrated.
Seaweed is used in many countries for very different purposes - directly as food, especially in sushi, as a source of phycocolloids, extraction of ... |
cena:
979,55 |
 |
Einhaltung der Hygiene- und Sicherheitsrichtlinien bei der Verarbeitung von Fleischprodukten (Unterweisung Fleischer/-in)
ISBN: 9783656868934 / Niemiecki / Miękka / 24 str. Termin realizacji zamówienia: ok. 5-8 dni roboczych. Unterweisung / Unterweisungsentwurf aus dem Jahr 2011 im Fachbereich AdA Handwerk / Produktion / Gewerbe - Lebensmittelverarbeitung, Note: 1,7, Sprache: Deutsch, Abstract: Mit Hilfe dieser Unterweisungsprobe soll es dem Auszubildenden moglich sein, neue Fertigkeiten und Fahigkeiten im Ausbildungsberuf zum Fleischer/ zur Fleischerin zu Erlernen. Hierbei soll der Auszubildende lernen Fleischprodukte zu verarbeiten. Zudem wird hierbei explizit auf die Hygienebestimmungen und Sicherheitsrichtlinien eingegangen.
Unterweisung / Unterweisungsentwurf aus dem Jahr 2011 im Fachbereich AdA Handwerk / Produktion / Gewerbe - Lebensmittelverarbeitung, Note: 1,7, Sprach...
|
cena:
147,68 |
 |
Handbook of Clinical Nutrition and Stroke
ISBN: 9781627039390 / Angielski / Miękka / 310 str. Termin realizacji zamówienia: ok. 5-8 dni roboczych. Handbook of Clinical Nutrition and Stroke is a comprehensive reference on nutrition for the multidisciplinary team caring for stroke patients. Targeting physicians, nurse practitioners, clinical dietitians, and advanced allied health and medical students, this volume provides an introduction on the different types of stroke, associated risk factors, and uniquely featured global perspectives on stroke. In addition to discussing stroke risk factors, the book expands upon treatment and management from the acute care setting through rehabilitation, captures the lifespan of patients affected by...
Handbook of Clinical Nutrition and Stroke is a comprehensive reference on nutrition for the multidisciplinary team caring for stroke patients. Targeti...
|
cena:
442,79 |
 |
Tropical Food Chains: Governance Regimes for Quality Management
ISBN: 9789086860272 / Angielski Termin realizacji zamówienia: ok. 5-8 dni roboczych. International supply chains of vulnerable tropical food products face major problems in the fields of quality performance and coordination between supply chain partners. Degradation and variability of quality, segmentation of supply networks and scattered production by smallholder producers could severely hinder reliable deliveries at required standards. Concerted efforts for improving governance regimes and management practices are required to enhance supply chain performance. This book provides a comprehensive overview of the interfaces between market outlet choice, supply chain governance,...
International supply chains of vulnerable tropical food products face major problems in the fields of quality performance and coordination between sup...
|
cena:
350,57 |
 |
Calcium: Chemistry, Analysis, Function and Effects
ISBN: 9781849738873 / Angielski / Twarda / 666 str. Termin realizacji zamówienia: ok. 5-8 dni roboczych. Calcium's importance in health and disease is clear when listing its multiple roles in the body, which include building strong bones and teeth, vascular calcification, muscle function, hormonal regulation and maintaining a normal heartbeat. This book will examine these roles and will also cover areas such as chemical analysis, sources of calcium based on geography, influence of Vitamin D, hypercalcemia and the effects of dietary calcium. This edited volume will pool knowledge across scientific disciplines in a way that increases its applicability to a wide range of audiences and fills the gap...
Calcium's importance in health and disease is clear when listing its multiple roles in the body, which include building strong bones and teeth, vascul...
|
cena:
1025,94 |
 |
Smart Milan: Innovations from Expo to Expo (1906-2015)
ISBN: 9783319172620 / Angielski / Miękka / 236 str. Termin realizacji zamówienia: ok. 5-8 dni roboczych. This book celebrates Milan s hosting of the World Exposition (Expo) in 2015 by providing fascinating insights into the city and its history that will appeal to all those visitors to Expo 2015 who wish to understand fully what Milan has to offer and what they are to see there. Combining straightforward language with academic thoroughness, the book traces the evolution of Milan from the previous Expo in 1906 through to the present day. Readers will learn about the innovative contributions made by Milan in many fields, including industry, architecture, scientific research, culture, fashion,... This book celebrates Milan s hosting of the World Exposition (Expo) in 2015 by providing fascinating insights into the city and its history that wi... |
cena:
100,60 |
|
Biotechnology
ISBN: 9783110341102 / Angielski / Miękka / 458 str. Termin realizacji zamówienia: ok. 5-8 dni roboczych. Biotechnology is the technical application that uses living organisms or biological systems to make products that have a profound impact on agriculture, environment, and human health. Biotechnology is the technical application that uses living organisms or biological systems to make products that have a profound impact on agricul... |
cena:
297,24 |
 |
Cooking for Geeks, 2e
ISBN: 9781491928059 / Angielski / Miękka / 488 str. Termin realizacji zamówienia: ok. 5-8 dni roboczych. Why do we cook the way we do? Are you the innovative type, used to expressing your creativity instead of just following recipes? Do you want to learn to be a better cook or curious about the science behind what happens to food as it cooks? More than just a cookbook, Cooking for Geeks applies your curiosity to discovery, inspiration, and invention in the kitchen. Why do we bake some things at 350F/175C and others at 375F/190C? Why is medium-rare steak so popular? And just how quickly does a pizza cook if we overclock an oven to 1,000 F/540 C? Author and cooking geek Jeff Potter... Why do we cook the way we do? Are you the innovative type, used to expressing your creativity instead of just following recipes? Do you want to lea... |
cena:
173,37 |
 |
Postharvest Management and Processing Technology
ISBN: 9789351241577 / Angielski / Twarda / 452 str. Termin realizacji zamówienia: ok. 5-8 dni roboczych. The postharvest management and processing technology of cereals, pulses, oilseeds, fruits and vegetables are under development. The postharvest losses of cereals, pulses, oilseeds are 10-20 per cent but the losses of fruits and vegetables in India vary from 20-30 per cent of the production. If these losses are controlled by using postharvest management and processing technology, the supplies of fresh fruits and vegetables will be increased to the extent of their existing losses. This will help to increase the per capita availability of fruits and vegetables. One object of this book is to...
The postharvest management and processing technology of cereals, pulses, oilseeds, fruits and vegetables are under development. The postharvest losses...
|
cena:
526,01 |
 |
Pineapple: Production and Processing
ISBN: 9789351241454 / Angielski / Twarda / 330 str. Termin realizacji zamówienia: ok. 5-8 dni roboczych. This book is offering comprehensive coverage of "Pineapple: Production and Processing" which will be useful for horticulturists, processors, entrepreneurs, orchardists, scientists, UG and PG students. The book integrates detailed information on botany, taxonomy, breeding, propagation, nutrition, physiology flowering and fruiting, plant protection measures, on farm handling, post harvest management, maturity indices, safe harvesting processing and technology for making value added products. Subject matter is described from the preliminary to the present level of knowledge in a systematic...
This book is offering comprehensive coverage of "Pineapple: Production and Processing" which will be useful for horticulturists, processors, entrepren...
|
cena:
404,62 |
 |
Food Policy: Looking Forward from the Past
ISBN: 9781439880241 / Angielski / Twarda / 510 str. Termin realizacji zamówienia: ok. 5-8 dni roboczych. Access to safe, adequate, and nutritionally balanced food is a cornerstone of public health. Food Policy: Looking Forward from the Past examines the influences of grassroots movements, the government, and industry on the US food systems. The authors explore the intersection of food and nutrition and how policy influences this overlap. They illuminate how current food policies stem from choices made (or abandoned) along the way. Sprinkled throughout the book are challenging questions meant to evoke critical analysis and inspire further, in-depth exploration. Although the book focuses... Access to safe, adequate, and nutritionally balanced food is a cornerstone of public health. Food Policy: Looking Forward from the Past examines th... |
cena:
881,59 |
 |
Valorization of Wine Making By-Products
ISBN: 9781482255331 / Angielski / Twarda / 365 str. Termin realizacji zamówienia: ok. 5-8 dni roboczych. An overview of wine making by-products and their conventional and non-conventional uses, Valorization of Wine Making By-Products gives you a deeper understanding of recovery processes that are a part of the new philosophy of sustainable agriculture. In line with the worldwide movement toward sustainable development, this book examines how to convert waste into useful products and to recycle waste products. It provides the research underpinning the processes and highlights new value-adding valorization technologies. Although vine cultivation and vinification generate a... An overview of wine making by-products and their conventional and non-conventional uses, Valorization of Wine Making By-Products gives you a... |
cena:
1150,97 |
 |
Nutritional Intervention in Metabolic Syndrome
ISBN: 9781466556829 / Angielski / Twarda / 454 str. Termin realizacji zamówienia: ok. 5-8 dni roboczych. The prevalence of metabolic syndrome (MS) is rising in developing countries and developed countries at such high rates that it is now considered a worldwide public health problem of pandemic proportions. Yet its spread can usually be mitigated by diet and lifestyle behavior. Nutritional Intervention in Metabolic Syndrome brings together coverage of dietary patterns and dietary components to create a complete understanding of the mechanisms by which these diets and components may improve metabolic syndrome. It then presents information on how to treat MS through lifestyle change and... The prevalence of metabolic syndrome (MS) is rising in developing countries and developed countries at such high rates that it is now considered a ... |
cena:
930,57 |
 |
Nutritional Biochemistry: Current Topics in Nutrition Research
ISBN: 9781771881456 / Angielski / Twarda / 302 str. Termin realizacji zamówienia: ok. 5-8 dni roboczych. Nutrition is becoming ever more central to our understanding of metabolic processes. Nutritional biochemistry offers insight into the mechanisms by which diet influences human health and disease. This book focuses on five aspects of this complex field of study: nutritional genomics, clinical nutrition and biochemistry, vitamins and minerals, macronutrients and energy, and cell function and metabolism. Collected in this research compendium are recent studies within each of these topics. Each chapter contributes to a well-rounded and up-to-date picture of nutritional biochemistry.... Nutrition is becoming ever more central to our understanding of metabolic processes. Nutritional biochemistry offers insight into the mechanisms by... |
cena:
587,73 |
 |
Supply Chain Management for Sustainable Food Networks
ISBN: 9781118930755 / Angielski / Twarda / 328 str. Termin realizacji zamówienia: ok. 5-8 dni roboczych. An interdisciplinary framework for managing sustainable agrifood supply chains Supply Chain Management for Sustainable Food Networks provides an up-to-date and interdisciplinary framework for designing and operating sustainable supply chains for agri-food products. Focus is given to decision-making procedures and methodologies enabling policy-makers, managers and practitioners to design and manage effectively sustainable agrifood supply chain networks. An interdisciplinary framework for managing sustainable agrifood supply chains Supply Chain Management for Sustainab... |
cena:
365,78 |
 |
Heat Pump Dryers: Theory, Design and Industrial Applications
ISBN: 9781498711333 / Angielski / Twarda / 345 str. Termin realizacji zamówienia: ok. 5-8 dni roboczych. Explore the Social, Technological, and Economic Impact of Heat Pump Drying Heat pump drying is a green technology that aligns with current energy, quality, and environmental concerns, and when compared to conventional drying, delivers similar quality at a lower cost. Heat Pump Dryers: Theory, Design and Industrial Applications details the progression of heat pump drying from pioneering research and demonstration work to an applied technology and establishes principles and theories that can aid in the successful design and application of heat... Explore the Social, Technological, and Economic Impact of Heat Pump Drying Heat pump drying is a green tec... |
cena:
808,12 |
 |
Genetically Modified Organisms in Food: Production, Safety, Regulation and Public Health
ISBN: 9780128022597 / Angielski / Twarda / 516 str. Termin realizacji zamówienia: ok. 5-8 dni roboczych. Genetically Modified Organisms in Food focuses on scientific evaluation of published research relating to GMO food products to assert their safety as well as potential health risks. This book is a solid reference for researchers and professionals needing information on the safety of GMO and non-GMO food production, the economic benefits of both GMO and non-GMO foods, and includes in-depth coverage of the surrounding issues of genetic engineering in foods. This is a timely publication written by a team of scientific experts in the field who present research results to help further... Genetically Modified Organisms in Food focuses on scientific evaluation of published research relating to GMO food products to assert their ... |
cena:
538,76 |
 |
Nutritional and Physiological Functions of Amino Acids in Pigs
ISBN: 9783709117170 / Angielski / Miękka / 307 str. Termin realizacji zamówienia: ok. 5-8 dni roboczych. Focusing on the gastrointestinal tract, this book offers developmental data on piglets, data on amino acid metabolism, nutritional and physiological functions of amino acids, signaling, research methodology and the pig as model for the study of human diseases.
Focusing on the gastrointestinal tract, this book offers developmental data on piglets, data on amino acid metabolism, nutritional and physiological f...
|
cena:
603,81 |
 |
Green Coffee Bean Extract in Human Health
ISBN: 9781498716376 / Angielski / Twarda / 240 str. Termin realizacji zamówienia: ok. 5-8 dni roboczych. The role of green coffee bean (GCB) in human health is of emerging interest to the nutraceutical field, especially given its role in improving metabolic syndrome, including weight management, hypertension, diabetes, and neuroprotection. GCB extract contains a novel antioxidant known as chlorogenic acid (also caffeoylquinic acid), which has been shown to positively affect blood pressure, brain health, diabetes, and weight management. This book provides information on the diverse health benefits of green coffee bean extract, molecular mechanisms and signaling pathways, safety of GCB, dosage,... The role of green coffee bean (GCB) in human health is of emerging interest to the nutraceutical field, especially given its role in improving meta... |
cena:
979,55 |













